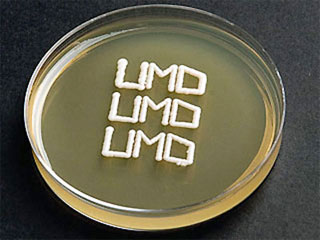
In tế bào gốc 3-D bằng hộp mực in phun

Sinh vật học
Sinh vật học
Khám phá những tin mới nhất về sinh vật học, khoa học về sự sống các loài động vật, thực vật kèm theo các hình ảnh tuyệt đẹp mới nhất về các loài động thực vật

Bí ngô nặng 686 kg
Vừa qua, quả bí ngô giống Atlantic Giant của anh Thad Starr nặng 686 kg đã phá vỡ tất cả các kỷ lục trước đó của vùng Half Moon Bay tại Cuộc thi Vô địch thế giới về trọng lượng bí ngô. Quả bí ngô này đã đem lại cho Thad Starr phần thưởng trị giá 9.144 USD.
Đăng ngày: 22/10/2007

Dây thần kinh mới được phát triển từ tế bào mỡ
Các nhà nghiên cứu tại Đại học Manchester (Anh) đã tạo ra dây thần kinh mới được phát triển từ tế bào gốc lấy từ mỡ của chuột, một tiến bộ có thể sẽ được dùng để sửa chữa các dây thần kinh ngoại vi bị tổn thương hoặc bị tai nạn.
Đăng ngày: 21/10/2007

Công bố chi tiết bản đồ biến thể gene người
Tạp chí khoa học Tự nhiên (Anh) ngày 17-10 cho biết một nhóm các nhà khoa học quốc tế vừa công bố bản đồ biến thể gene người được đánh giá là chi tiết và hoàn chỉnh nhất từ trước tới nay.
Đăng ngày: 19/10/2007

Nhân giống thành công loài cổ thực vật sắp tuyệt chủng
Lần đầu tiên, các nhà khoa học đã thành công trong việc nhân giống trong ống nghiệm đối với Thủy tùng Việt Nam – loài cổ thực vật được xem như hóa thạch sống của ngành Hạt trần.
Đăng ngày: 17/10/2007

Dùng vi khuẩn tạo sơn óng ánh như ngọc trai
Một kỹ thuật mới sử dụng vi sinh vật có thể mang lại các giải pháp rẻ tiền và an toàn hơn trong việc tạo ra mỹ phẩm hay sơn có màu sắc óng ánh của ngọc trai cũng như các loại nhựa đa sắc.
Đăng ngày: 17/10/2007

Vì sao lá cây đổi màu?
Trong nhiều năm nay, các nhà khoa học vẫn tự hỏi làm thế nào mà lá cây chuẩn bị cho màn trình diễn sắc màu rực rỡ trong mùa thu. Các phân tử đằng sau màu vàng và cam thì đã được hiểu rõ, nhưng s
Đăng ngày: 17/10/2007
In tế bào gốc 3-D bằng hộp mực in phun
Các nhà khoa học Mỹ đang sử dụng hộp mực in phun để in cấu trúc 3 chiều của tế bào gốc, góp phần đẩy mạnh việc giải mã ngôn ngữ tế bào để phục vụ cho các mục đích y học.
Đăng ngày: 14/10/2007

Băng keo “chân ếch” dùng nhiều lần
Bạn muốn có một loại băng keo có thể sử dụng được nhiều lần? Các nhà khoa học Ấn Độ sẽ giúp bạn toại nguyện bằng một loại băng keo đặc biệt, được mô phỏng theo cấu trúc gan bàn chân của loài ếch cây.
Đăng ngày: 13/10/2007

Trồng lúa khô giàu chất dinh dưỡng thay lúa nước
Một phương pháp trồng lúa mới giúp tiết kiệm được hàng tỷ mét khối nước mà vẫn đảm bảo an ninh lương thực vừa được thử nghiệm thành công. Đó là những cây mạ giàu chất dinh dưỡng và khô thay vì những cây mạ nước.
Đăng ngày: 13/10/2007

Loài vật nhịn sex... 40 triệu năm
Một nhóm cư dân tí hon của trái đất đã sống sót mà không màng đến chuyện "yêu đương" trong suốt hàng chục triệu năm, nhờ vào một thủ thuật tiến hoá tin
Đăng ngày: 12/10/2007

Chất dẻo sinh học làm từ đường
Chất dẻo sinh học từng được sản xuất tại nhiều nước nhưng với nguồn gốc từ ngũ cốc. Mấy năm qua, giá ngũ cốc đã tăng cao do nhu cầu nhiên liệu sinh học tăng mạnh. Dự án Bio-On có nhiều thuận lợi hơn nhờ sự đa dạng của các nguyên liệu..
Đăng ngày: 08/10/2007

Đã tạo được nhiễm sắc thể nhân tạo?
Nhà nghiên cứu người Mỹ Craig Venter vừa khiến giới khoa học xôn xao khi tuyên bố đã tạo ra được sự sống nhân tạo. Thành tựu này, theo ông Venter, sẽ là thần dược cứu chữa nhiều loại bệnh tật của loài người, và thậm chí phát triển
Đăng ngày: 08/10/2007

Khoai tây chuyển gien dùng làm giấy
Hiện nay, ngành sinh học công nghệ đang nóng lên vì loại khoai tây biến đổi gien. Nếu được thông qua, loại khoai tây chuyển gien này sẽ là sản phẩm chuyển gien đầu tiên được triển khai tại các nông trại châu Âu.
Đăng ngày: 08/10/2007

Màn lừa đảo bốc mùi của cây mè cổ đại
Một trong những loài thực vật cổ nhất trái đất - cây mè - sử dụng một thứ mùi nồng nặc, hơi nóng và một chút lừa đảo để quyến rũ các con côn trùng thụ phấn cho chúng.
Đăng ngày: 06/10/2007

Vi sinh vật: “Chuyên gia cao cấp” xử lý ô nhiễm môi trường
Công nghệ vi sinh vật đã và đang là công cụ đắc lực và rẻ tiền nhất, hỗ trợ cho con người trong cuộc chiến cam go: bảo vệ môi trường.
Đăng ngày: 04/10/2007

Tranh cãi về sự có mặt của dạng sống siêu nhỏ
Các nhà khoa học Mỹ đã phát hiện trong động mạch bị vôi hóa có những khối cầu chỉ bé bằng 1/5 so với sinh vật nhỏ nhất. Họ cho rằng đó cũng là một dạng của sự sống. Tồn tại hay không những dạng sống khác ở thế giới siêu nhỏ nano? Đó vẫn là b&ag
Đăng ngày: 04/10/2007
Tiêu điểm




